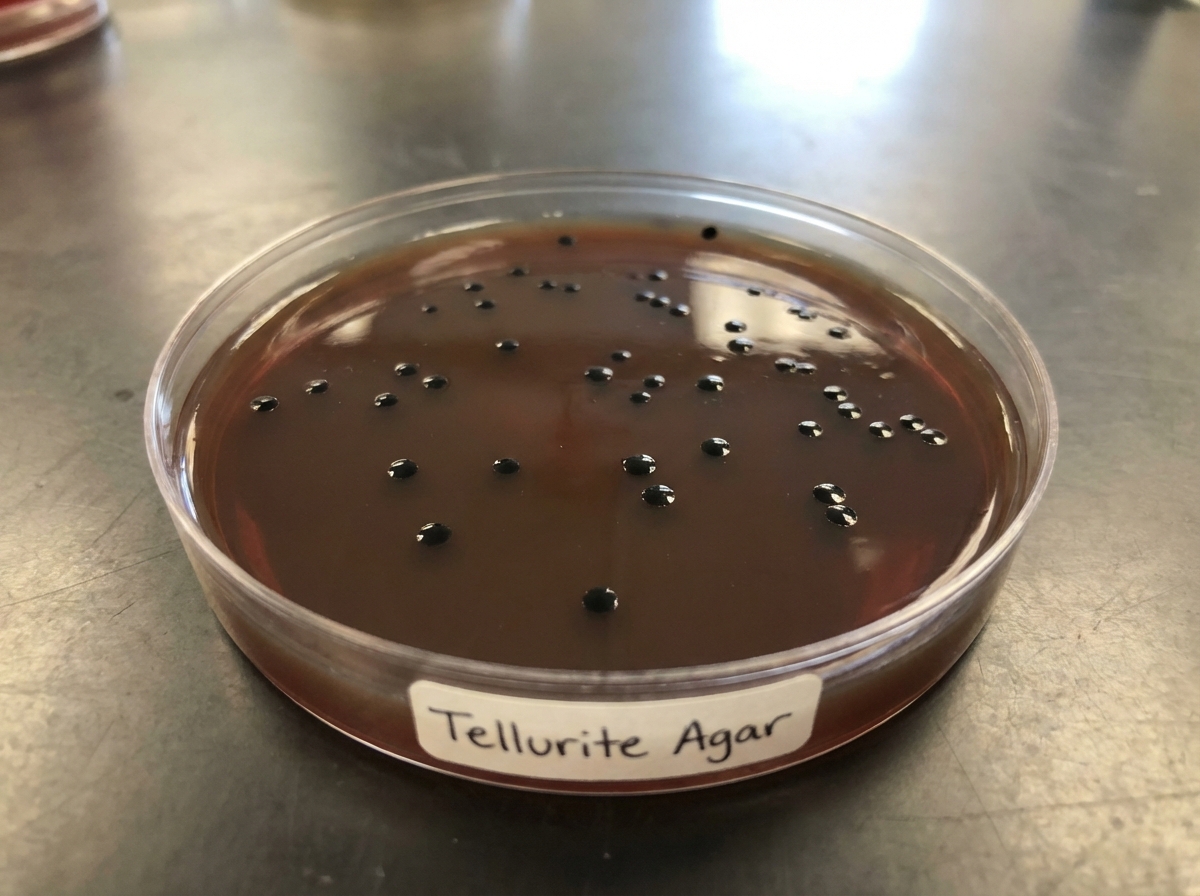
Image for question 405

Milk-Alkali syndrome may be caused by ingestion of
Which condition can present both as nephritic syndrome and nephrotic syndrome?
Chronic kidney disease is defined as the presence of a diminished GFR for at least?
A 20-year-old smoker presents with hemoptysis and hematuria. What is the most likely diagnosis?
A 60-year-old male with a history of COPD and heart failure presented with shortness of breath and signs of right-sided heart failure. He was catheterized and initiated on treatment. After 8 days, he developed right flank pain, high-grade fever, and rigors. Examination revealed cloudy urine in the catheter and pain in the urethral region. Urine microscopy and culture were performed. Ultrasound of the abdomen showed pyelonephritis of the right kidney. Urine studies indicated increased WBCs. The isolated organism, when Gram stained, showed tiny deep pink colonies on MacConkey agar. Colonies grown on tellurite agar are provided. The organism is heat-resistant and can grow in 40% bile, 6.5% NaCl, and at pH 9.6. To which of the following drugs is this organism intrinsically resistant?
Hyperkalemia is caused by which of the following conditions?
What is the GFR (mL/min per 1.73m2) for a patient in stage IV of chronic kidney disease?
Which of the following is NOT a feature of Chronic Renal Failure?
A 42-year-old female presents with diazepam and alcohol overdose. She is comatose with a temperature of 34.5°C, BP of 100/80 mmHg, and creatinine of 2.4 mg/dL. Her AST is 500 IU/L and GGT is 35 IU/L. Urine dipstick showed 3+ for blood, but urine analysis was normal. Ultrasound abdomen was normal. What is the most likely diagnosis?
A 45-year-old patient on hemodialysis for one week has noted that his blood pressure is more difficult to control. He reports good compliance with his medications, which include erythropoietin, ferrous sulfate, vancomycin, and vitamin D. His blood pressure is 180/99 mm Hg. What is the most likely cause for the worsening control of his blood pressure?
Acute Kidney Injury
Practice Questions
Chronic Kidney Disease
Practice Questions
Glomerular Diseases
Practice Questions
Tubulointerstitial Diseases
Practice Questions
Nephrotic and Nephritic Syndromes
Practice Questions
Urinary Tract Infections
Practice Questions
Renal Replacement Therapy
Practice Questions
Fluid and Electrolyte Disorders
Practice Questions
Acid-Base Disorders
Practice Questions
Kidney in Systemic Diseases
Practice Questions
Kidney Stones and Obstructive Uropathy
Practice Questions
Hypertension in Kidney Disease
Practice Questions
Get full access to all questions, explanations, and performance tracking.
Scan to download app